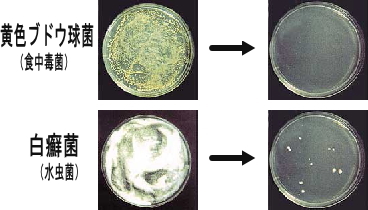
抗菌効果テスト

24時間受注、毎日出荷(土日祝日除く)
- 2020年5月7日 「銀のきらめき250」新規入庫しました。容器の仕様は予告なく変更する場合があります。
- 2020年5月7日 「銀のきらめき500」は在庫ゼロとなりました。「銀イオンバッグ」は在庫あります。
- 2020年4月8日 「銀イオンバッグ」は販売しております。
- 2020年4月8日 コロナウイルスの影響で注文が殺到しており品薄状態です。
- 2020年2月29日 商品が品薄になっております。
- 2016年1月10日 銀のきらめき250をスプレーガンに変更しました。
- 2016年5月5日 サイトを大幅更新しました。
- 2016年5月25日 梅雨の除菌対策追加しました。
- 2016年5月26日 使い方おすすめを追加しました。
- 2016年12月21日 大掃除は「銀のきらめき」で安心安全を追加しました。
現在コロナウイルスの影響で、スプレーガンが品薄状態です。
銀イオンバッグをお買い求めの上、市販やお持ちのボトルで銀イオン水はご利用頂けます。
銀イオンバッグの入ったボトルに水道水を入れるだけ。
スプレーするだけで、除菌します。
銀イオン水に化学物質が一切含まれないので安心
無臭なので嫌なにおいが残りません。
ペンシルベニア大学で認められた抗菌力

AGpossとは右の写真のような99.9%の銀でメッキされた繊維です。
1986年にAGpossと同じ銀メッキ繊維を使った大腸菌など7種類の代表的な菌の培養試験で、1時間以内に死滅するか、著しく減少することが確認されました。
その後も東海大学などの菌の培養試験で、同様の効果が確認されました。
「銀のきらめき」はAGpossを使用した唯一の銀イオンスプレーです。
AGpossの安全で高い抗菌性を備えた、銀イオンスプレーは「銀のきらめき」だけです。
20年以上に渡り研究、実験され、その抗菌性が実証されてきました。

銀イオンだけの安全で経済的な高性能抗菌スプレー
銀のきらめきは銀イオンと水だけの安全で抗菌性の高い、銀イオン抗菌スプレーです。
作り方は簡単
銀イオンバッグが入ったスプレーボトルに水道水を入れて10~20回振ると10分後には銀イオン水ができます。
そして付属の銀イオンバッグで75リッター(銀のきらめき250で300本分)の銀イオン水を作ることができます。
安全でクリーン
銀のきらめきの銀イオン水は、無色透明、無味無臭、化学物質を一切含まない安全性の高い、クリーンな抗菌水です。
ですから、人体や顔面にも安心してお使いいただけます。
安全性については銀イオンの安全性をご参考ください。
高い経済性
そしてコストを気にせずにたっぷりお使い頂くため、250ccボトル1本
1、990円(税込)という低価格でご提供させて頂いております。
是非、家庭の常備銀イオン抗菌スプレーとしてお使いいただければ幸いです。
「銀のきらめき」は長い間お使いいただく程その良さが、お分かりいただけます。「銀のきらめき」はあなた様の清潔・安全・安心な生活をサポートします。
僅か10分で銀イオン水が生成
銀イオンバッグが入ったボトルに水道水を入れて20回程度攪拌するだけ、銀イオン水が生成します。(水温や容量によって違う場合があります。)
高い抗菌効果は十分な銀イオン濃度から
AGposs「銀のきらめき」の銀イオン水の中は水以外は銀イオンだけ。
純度99.9%の銀メッキ繊維から溶出するの銀イオン水の濃度は約100ppb~です。※1)
抗菌効果を得るための、銀イオンの濃度は5~10ppbですから、「銀のきらめき」には高い抗菌効果があるのです。
(※1)ppbとは…濃度や割合を表す単位で「part per billion」 の略です。
銀イオンバッグ+水道水=銀イオン
「銀のきらめき」のボトルの中には銀イオンバッグが入っています。
この銀イオンバックの中身は銀メッキ繊維です。
純度99.9%の銀だけで覆われている繊維です。
銀イオンバッグの入ったボトルに水道水を入れ約20回振るだけで銀イオン水が出来上がります。
250CC1本がわずか6.6円。約1年間使用できます。
250CCのボトルで約300回(または1年)も使用できます。
価格は1,990円ですから、1回当たりなんと6.6円です。コストを気にせず使うことができます。
高い抗菌効果
黄色ブドウ球菌、メチシリン耐性黄色ブドウ球菌、大腸菌、肺炎桿菌、緑膿菌、
カンジダなどの身の回りの殆どの細菌に対して、抗菌効果があります。
下記には黄色ブドウ球菌と白癬菌のテスト結果です。
黄色ブドウ球菌は初期から1時間経過後、白癬菌は18時間経過後の実験写真です。
少ない銀の含有量で大きくて、早い抗菌効果
AGpossの抗菌効果は少ない銀の量で大きな抗菌効果が得られるところに特長があります。AGpossによって生成される、銀イオン水は抗菌効果を得られるに十分な濃度の銀イオンが容易に素早く得られるので、下記のグラフのように
抗菌作用で大きな効果が得られます。

銀イオンが出ている証拠
水道水には消毒のため次亜塩素酸が入っていますが、「銀のきらめき」の銀イオンバックをその中に入れ、攪拌すると、銀イオンが発生し、次亜塩素酸と反応し、塩化銀になります。
水道水が安全な抗菌作用を持つ水に変化したようすが、下記の動画です。
水道水10ccにオルトトリジン液を3滴加えると、次亜塩素酸を検知して黄色くなります。
そして、銀イオンバッグを入れ攪拌すると無色透明になるのがわかります。
野菜やお肉も洗える高い安全性
AGposs銀イオンスプレー「銀のきらめき」は銀イオンしか溶出しないため、非常に安全です。
ですから安心して、高い抗菌効果が得られるのです。
下の写真をクリックすると、使用例をみることができます。






